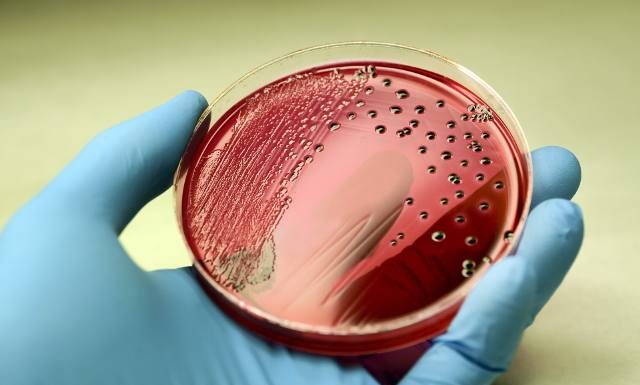
Salmonella to groźna bakteria nie tylko z żywności. Zobacz, jakie są objawy zatrucia Salmonellą, jak uniknąć zakażenia oraz jak je leczyć

Dodatkowe opłaty w szpitalach. Oto lista wydatków, które poniesiemy w placówce medycznej. Pobyt w szpitalu to nic przyjemnego, a zdarza się, że trzeba tam spędzić więcej czasu, niż się zakładało. Przebywając w określonej placówce medycznej, musimy liczyć się z...
Bób to smaczna i łatwa w przygotowaniu przekąska. Może być jedzony solo lub jako składnik sałatek lub past. Sezon na niego trwa od czerwca do lipca. Warto wówczas gotować bób oraz zamrażać go na pozostałe miesiące, aby cieszyć się...
Moderna pracuje nad szczepionką 2w1, czyli przeciwko grypie i Covidowi. Firma zaznacza, że szczepionka ta przeszła już znaczną część kontroli na ostatnim etapie.
Źródło: klik
Salmonella to groźna bakteria, która wywołuje zatrucie pokarmowe. Występuje wręcz powszechnie w surowych produktach odzwierzęcych, dlatego przy ich przechowywaniu i przygotowaniu trzeba zachować zasady higieny. To jednak niejedyne źródła zakażenia salmonellozą, bo zarazić można się też od drugiego człowieka...
Poziomki to pyszne owoce, które rzadko można spotkać na targach czy w warzywniakach. Najsmaczniejsze i najwartościowsze poziomki znajdziesz w lesie. Możesz też uprawiać je w doniczkach na balkonie czy w ogródku. Poziomki są smaczne i aromatyczne, a do tego...
Latem delikatna skóra dziecka potrzebuje szczególnej troski. Szkodliwe promienie słoneczne mogą powodować oparzenia, przesuszenie i podrażnienia. Aby temu zapobiec, przed wyjazdem na wakacje czy wizytą na placu zabaw należy nałożyć na odsłonięte części ciała malucha krem z wysokim filtrem...
Dodatkowe opłaty w szpitalach. Oto lista wydatków, które poniesiemy w placówce medycznej. Pobyt w szpitalu to nic przyjemnego, a zdarza się, że trzeba tam spędzić więcej czasu, niż się zakładało. Przebywając w określonej placówce medycznej, musimy liczyć się z...
Większość z nas używa go na co dzień, do pracy, kontaktu z bliskimi, dla rozrywki. Bez smartfona trudno wyobrazić sobie teraz życie. To niewielkie urządzenie nie tylko ułatwia funkcjonowanie, lecz – jak informuje lekarka i instagramerka – może też...
"Dostępna stomatologia" to nazwa programu, dzięki któremu leczenie zębów będzie dostępniejsze dla niepełnosprawnych Polaków. Państwowy Fundusz Rehabilitacji Osób Niepełnosprawnych szuka partnera, z którym wystąpi o unijne fundusze mające sfinansować działania w latach 2024-2027.
Źródło: klik
Zespół Klinicznego Oddziału Elektrokardiologii Uniwersyteckiego Szpitala Klinicznego Nr 4 w Lublinie po raz pierwszy w woj. lubelskim wszczepił nowatorski rozrusznik AVEIR (VR). - Zaletą nowej metody jest to, że stymulator po zakończeniu swojej pracy jest w pełni usuwalny, a w...